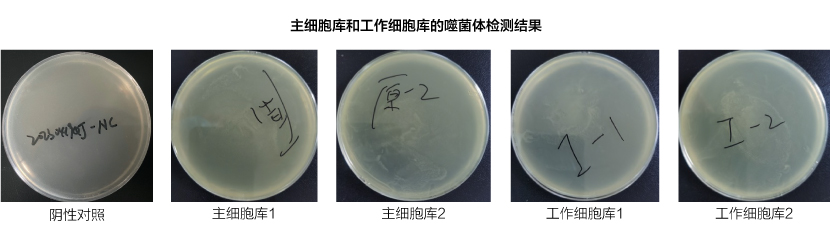
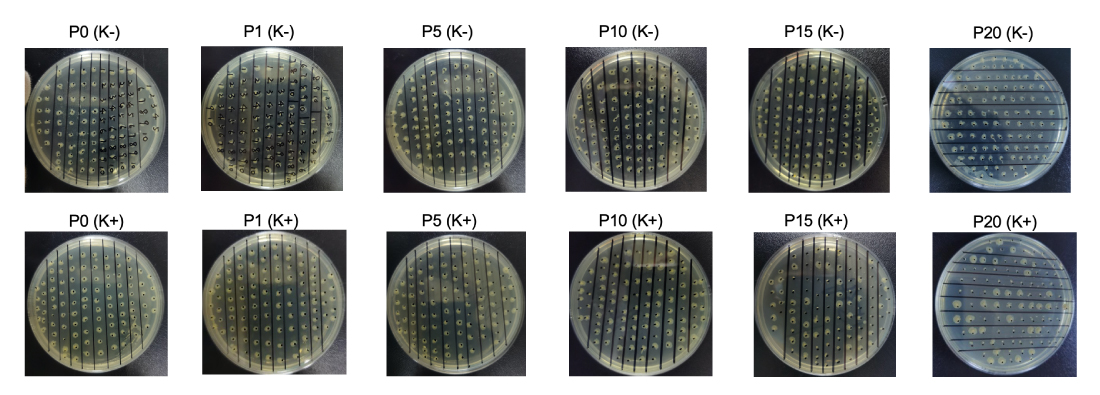

T7 RNA聚合酶篩選 (高通量)
客戶需求:交付一步純化的突變體

| 客戶要求 | 樣品數量 | 交付周期 | 表達規模 | 質控檢測 | ||
|---|---|---|---|---|---|---|
| 交付一步純化的突變體 | 76個 | 22個工作日 | 50 mL | A280 | SDS-PAGE | 完整分子量 (隨機挑選5個) |
76個RNA聚合酶表達數據統計


1. 候選酶篩選(高通量表達)

表達體積:4-50mL
表達產能:700個樣品/周
評估蛋白表達水平和溶解度
可以在未經純化的樣品或低純度樣品中進行酶活性測試
2. 候選酶篩選(小規模表達)

表達體積:1L (燒瓶) 或5L (發酵罐)
表達產能:200個樣品/周
純化后的產量和質量數據
檢測雜質是否會影響測試
小規模表達再次確認候選物
3. 細胞庫構建

載體和菌株篩選,以及密碼子優化
WCB 10-50代傳代穩定性測試:質粒丟失率&表達水平
利用 (DLA) 技術對主細胞庫和工作細胞庫的噬菌體進行檢測
周期性測試工作細胞庫的活力和表達水平,以確定保存時間
4. 上游工藝開發

表達量:20-500L(發酵罐)
發酵工藝:高密度
細胞密度 (OD 600) > 200
5. 下游工藝開發

His標簽蛋白或無標簽蛋白; 純度 (HPLC): 高至99%
內毒素水平: <1EU /mg; 產量:高至15 g/L)
6. 分析方法開發

7. 制劑開發

候選緩沖液的性能將在應力條件下進行測試,并在某些點檢查純度或活性
8. 穩定性評估

兩種壓力條件,一個月內檢查純度或活性4次
兩個加速條件,6個月內檢查純度或活性3次
在儲存條件下,24個月內檢查純度或活性9次
發貨狀況確認
9. 放大生產

T7 RNA聚合酶篩選 (高通量)
客戶需求:交付一步純化的突變體

| 客戶要求 | 樣品數量 | 交付周期 | 表達規模 | 質控檢測 | ||
|---|---|---|---|---|---|---|
| 交付一步純化的突變體 | 76個 | 22個工作日 | 50 mL | A280 | SDS-PAGE | 完整分子量 (隨機挑選5個) |
76個RNA聚合酶表達數據統計


T7 RNA聚合酶篩選 (1L表達規模)
客戶需求:90%純度, 交付量5mg, 去除核酸&核酸酶


用于基因編輯的X酶
項目目的:交付該基因編輯X酶的工作細胞庫

備注:選擇表達量突出的克隆構建MCB和WCB
1. 表達量評估 & 限制性酶切圖譜


結果:通過質粒表達水平評估和限制性檢查確認MCB和WCB
2. 噬菌體檢測
利用 (DLA) 技術對主細胞庫和工作細胞庫的噬菌體進行檢測
結果:主細胞庫和工作細胞庫中沒有噬菌體污染。
3. 質粒穩定性測試
抗生素加壓WCB細胞傳代培養 (P20)

結果:工作細胞庫的表達水平保持穩定,P1、P5、P10、P15 和 P20 代的SDS-PAGE結果沒有顯著降低。
無抗生素加壓WCB細胞傳代培養 (P20)
結果:工作細胞庫(P1、P5和P10)傳代中無明顯質粒丟失。
4. 長期細胞庫活力測試
測試工作細胞庫的活力和表達水平以確定細胞庫儲存時間。
| 檢測項 | 存儲時間檢查點 (月) | |||||
|---|---|---|---|---|---|---|
| 0 | 3 | 6 | 12 | 18 | 24 | |
| 細胞活力 | 通過 | 通過 | 進行中 | 進行中 | 進行中 | 進行中 |
| 表達水平 | 通過 | 通過 | 進行中 | 進行中 | 進行中 | 進行中 |
用于基因編輯的X酶
項目目的:對該基因編輯酶的細胞培養和純化工藝進行優化

| 階段 | 項目 | 批次 1 |
|---|---|---|
| 上游工藝開發 (細胞培養) | 細胞密度 (OD 600) | 102 |
| 濕菌重量 | 234 g/L | |
| 培養時間 | 22 h | |
| 下游工藝開發 (純化) | 外觀 | 澄清, 無色, 液體 |
| 濃度 | 12.45 mg/ml | |
| 純度 (SDS-PAGE) | >90% | |
| 純度 (RP-HPLC) | >95% | |
| 純度 (SEC-HPLC) | >95% | |
| 內毒素 | 1.7 EU/mg | |
| 宿主細胞殘留 (HCP) | 35.49 ng/mL | |
| 宿主DNA殘留 (HCD) | 0.06 ng/mL | |
| Residual DNAse |
| |
| 支原體檢測 | 陰性 | |
| 產量 | 29.2 mg/L |
用于體外診斷的X酶
項目目的:對該體外診斷酶的細胞培養和純化工藝進行優化

| 階段 | 項目 | 批次 1 |
|---|---|---|
| 上游工藝開發 (細胞培養) | 細胞密度 (OD 600) | 162 |
| 濕菌重量 | 250 g/L | |
| 培養時間 | 22 h | |
| 下游工藝開發 (純化) | 外觀 | 黃色粉末 |
| 濃度 | 50 mg/ml | |
| 純度 (SDS-PAGE) | >95% | |
| 純度 (SEC-HPLC) | >99% | |
| 水分 | 4.0 % | |
| 活性 | > 40 KU/g | |
| 產量 | > 4.5 g/L |

SDS-PAGE

SEC/RP-HPLC

E.coli 宿主DNA殘留檢測
qPCR assay kit

支原體DNA檢測
qPCR assay kit

內毒素檢測
Endotoxin LAL test

E.coli 宿主細胞殘留檢測
ELISA assay kit

脫氧核糖核酸酶殘留檢測
DNaseAlert? QC System

核糖核酸酶殘留檢測
RNaseAlert? QC System
MAD7酶活性方法

| 緩沖液1 | 緩沖液2 | |
|---|---|---|
| sgRNA1 | 82.3% | 91.3% |
| sgRNA2 | 62.6% | 87.9% |
| sgRNA3 | 84.3% | 93.3% |
| sgRNA4 | 42.7% | 66.8% |
| sgRNA5 | 68.8% | 93.0% |

| sgRNA | 酶 | 10分鐘 | 60分鐘 |
|---|---|---|---|
| sgRNA3(30nM) | MAD7(5 nM) | 84.3% | 90.1% |
| sgRNA3(30nM) | MAD7(15 nM) | 93.1% | 98.2% |
| sgRNA3(30nM) | MAD7(30 nM) | 97.9% | 98.4% |
MAD7存儲緩沖液篩選
| 簡稱 | 編號 | 緩沖液組成 | 來源 |
|---|---|---|---|
| P | Buffer 1 | 50 mM sodium phosphate, 300 mM NaCl, 0.1 mM EDTA, pH 7.5, 50 % (v/v)? glycerol and 1 mM TCEP | Rojek et al., 2021 |
| TA | Buffer 2 | 10 mM Tris (pH 7.4), 300 mM NaCl, 1 mM TCEP, and 50% (v/v) glycerol. | GenScript |
| TB | Buffer 3 | 10 mM Tris (pH 7.4), 300 mM NaCl, 1 mM TCEP, 0.1 mM EDTA, and 50% Glycerol | ABM |

MAD7的凍融檢測
| 起始材料 | -80°C 輕度凍融 (10次) | LN2快速凍融 (10次) | |
|---|---|---|---|
| 外觀 | 透明液體 | 透明液體 | 透明液體 |
| HPLC 純度 | >99% | >99% | >99% |
| A280 濃度 (mg/ml) | 11.40 | 11.55 | 10.76 |
| SDS-PAGE 純度 | 90% | 90% | 90% |
MAD7壓力穩定性檢測
| 0 天 | 5 天 | 10 天 | 30 天 | |
|---|---|---|---|---|
| 外觀 (15°C) | 澄清 | 澄清 | 澄清 | 澄清 |
| 純度 (15°C) | 99% | 99% | 99% | 99% |
| 外觀 (37°C) | 澄清 | 發白 | 發白 | 發白 |
| 純度 (37°C) | 99% | 91% | 85% | 71% |
MAD7加速穩定性檢測
| 0 月 | 3 月 | 6 月 | |
|---|---|---|---|
| 外觀 (5°C) | 澄清 | 進行中 | 進行中 |
| 純度 (5°C) | 99% | 進行中 | 進行中 |
| 外觀 (25°C) | 澄清 | 進行中 | 進行中 |
| 純度 (25°C) | 99% | 進行中 | 進行中 |
MAD7長期穩定性檢測
| 0 月 | 1 月 | 2 月 | 3 月 | 6 月 | 9 月 | 12 月 | 18 月 | 24 月 | |
|---|---|---|---|---|---|---|---|---|---|
| 外觀 | 澄清 | 澄清 | 澄清 | 進行中 | 進行中 | 進行中 | 進行中 | 進行中 | 進行中 |
| A280 濃度 (mg/ml) | 11.40 | 11.36 | 11.11 | 進行中 | 進行中 | 進行中 | 進行中 | 進行中 | 進行中 |
| HPLC 純度 | >99% | >99% | >99% | 進行中 | 進行中 | 進行中 | 進行中 | 進行中 | 進行中 |
問:定制化酶的開發和交付的常規交付周期是多久?
答:交付周期會因項目的復雜性和具體要求而有所不同,我們將由專業技術團隊進行評估以確定具體的交付時間。然而,我們一直致力于提供高效和及時的解決方案,通常情況下,我們能夠在數月內完成并交付您所需的定制酶產品。
問:機器學習在酶開發過程中扮演什么角色?
答:金斯瑞采用杰出的機器學習和深度學習技術來分析各類酶工程項目期間產生的大量數據集合,識別模型,并預測酶的行為。我們可以更高效地設計具有改進性能的酶,更好的滿足您的定制需求。
問:在進行酶開發項目的合作時,GenScript如何處理知識產權和保密問題?
答:我們高度重視知識產權和保密事項。我們的合作協議中包含了保護您的權益和確保敏感信息保密的條款。我們一直秉承嚴格的道德標準,致力于在合作中維護良好的倫理行為。
問:定制酶的生產規模是多少,如何確保不同生產規模的一致性?
答:我們可以根據您的具體需求擴大生產規模,無論是研究級別還是大型工業級別。我們擁有嚴格的質量控制流程,以確保在不同規模下的酶生產一致性。
問:GenScript如何及時了解酶開發和生物技術的最新進展?
答:我們擁有專門的研發團隊,不斷跟蹤該領域的最新動態。此外,我們與領先的專家和學術機構合作,以確保我們始終站在酶開發和生物技術創新的前沿。
